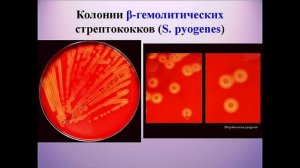

7:53
7:53
2024-01-02 22:48

 14:37
14:37

 14:37
14:37
2025-02-04 11:27

 23:53
23:53

 23:53
23:53
2023-12-06 20:51

 11:55
11:55

 11:55
11:55
2023-11-22 08:40

 10:16
10:16

 10:16
10:16
2024-07-29 20:58

 1:23
1:23

 1:23
1:23
2023-12-22 04:37

 3:52
3:52

 3:52
3:52
2023-11-25 11:03

 12:45
12:45

 12:45
12:45
2023-11-25 15:01

 12:08
12:08

 12:08
12:08
2023-12-22 00:23

 2:18
2:18

 2:18
2:18
2023-11-08 20:23

 5:53
5:53

 5:53
5:53
2023-12-06 14:50
![Часть 2. Кафедра биотехнологии и микробиологии наглядная микробиология]() 7:51
7:51
 7:51
7:51
2021-08-24 14:06

 7:31
7:31

 7:31
7:31
2023-09-15 10:16

 6:19
6:19

 6:19
6:19
2023-10-07 18:34

 15:57
15:57
15:57
15:57
2023-08-20 11:38

 2:41
2:41

 2:41
2:41
2023-04-03 15:56

 13:38
13:38

 13:38
13:38
2024-09-14 19:00

 3:30
3:30
![Анна Бершадская - Новая я (Премьера клипа 2025)]() 2:41
2:41
![Азиз Абдуллох - Аллохнинг айтгани булади (Премьера клипа 2025)]() 3:40
3:40
![Зафар Эргашов - Мусофирда каридим (Премьера клипа 2025)]() 4:58
4:58
![MARSO - Дура (Премьера клипа 2025)]() 3:05
3:05
![Рейсан Магомедкеримов - Забываю (Премьера клипа 2025)]() 3:20
3:20
![MIA BOYKA - А он такой (Премьера клипа 2025)]() 2:24
2:24
![Жалолиддин Ахмадалиев - Тонг отгунча (Премьера клипа 2025)]() 4:44
4:44
![Зара - Я несла свою беду (Премьера клипа 2025)]() 3:36
3:36
![ARTIX, SHAXO - Дождь (Премьера клипа 2025)]() 5:23
5:23
![TASSO - Таю (Премьера клипа 2025)]() 3:23
3:23
![Игорь Крутой - Зонтик (Премьера клипа 2025)]() 4:00
4:00
![Фати Царикаева - Стамбул (Премьера клипа 2025)]() 2:57
2:57
![Азимжон Сайфуллаев - Тупрок буламиз (Премьера клипа 2025)]() 4:38
4:38
![ARTEE - Лети (Премьера клипа 2025)]() 3:13
3:13
![MEDNA - Алё (Премьера клипа 2025)]() 2:28
2:28
![Динара Швец - Новая история (Премьера клипа 2025)]() 3:45
3:45
![Рейсан Магомедкеримов, Ренат Омаров - Бла-та-та (Премьера клипа 2025)]() 2:26
2:26
![INSTASAMKA - AGENT GIRL (Премьера клипа 2025)]() 3:24
3:24
![Taylor Swift - The Fate of Ophelia (Official Video 2025)]() 3:58
3:58
![Фаррух Хамраев - Отажоним булсайди (Премьера клипа 2025)]() 3:08
3:08
![Эффект бабочки | The Butterfly Effect (2003)]() 1:53:35
1:53:35
![Голый пистолет | The Naked Gun (2025)]() 1:26:24
1:26:24
![Тот самый | Him (2025)]() 1:36:20
1:36:20
![Терминатор 2: Судный день | Terminator 2: Judgment Day (1991) (Гоблин)]() 2:36:13
2:36:13
![Сколько стоит жизнь? | What Is Life Worth (2020)]() 1:58:51
1:58:51
![Девушка из каюты №10 | The Woman in Cabin 10 (2025)]() 1:35:11
1:35:11
![Вечеринка только начинается | The Party's Just Beginning (2018)]() 1:31:20
1:31:20
![Школьный автобус | The Lost Bus (2025)]() 2:09:55
2:09:55
![Голос любви | Aline (2020)]() 2:05:43
2:05:43
![Дикари | The Savages (2007)]() 1:54:19
1:54:19
![Французский любовник | French Lover (2025)]() 2:02:20
2:02:20
![Обитель | The Home (2025)]() 1:34:43
1:34:43
![Молода и прекрасна | Jeune & jolie (2013)]() 1:33:24
1:33:24
![Большое смелое красивое путешествие | A Big Bold Beautiful Journey (2025)]() 1:49:20
1:49:20
![Сумерки | Twilight (2008)]() 2:01:55
2:01:55
![Псы войны | Hounds of War (2024)]() 1:34:38
1:34:38
![Стив | Steve (2025)]() 1:33:34
1:33:34
![Плюшевый пузырь | The Beanie Bubble (2023)]() 1:50:15
1:50:15
![Долгая прогулка | The Long Walk (2025)]() 1:48:08
1:48:08
![Любимец женщин | Roger Dodger (2002)]() 1:41:29
1:41:29
![Агент 203]() 21:08
21:08
![Сборники «Простоквашино»]() 1:04:60
1:04:60
![Отважные мишки]() 13:00
13:00
![Простоквашино. Финансовая грамотность]() 3:27
3:27
![Пингвиненок Пороро]() 7:42
7:42
![Врумиз. 1 сезон]() 13:10
13:10
![Супер Дино]() 12:41
12:41
![Панда и петушок Лука]() 12:12
12:12
![Команда Дино Сезон 2]() 12:31
12:31
![Команда Дино. Исследователи Сезон 2]() 13:26
13:26
![Зомби Дамб]() 5:14
5:14
![Артур и дети круглого стола]() 11:22
11:22
![Лудлвилль]() 7:09
7:09
![Школьный автобус Гордон]() 12:34
12:34
![Паровозик Титипо]() 13:42
13:42
![Хвостатые песенки]() 7:00
7:00
![Супер Зак]() 11:38
11:38
![Полли Покет Сезон 1]() 21:30
21:30
![Корги по имени Моко. Новый питомец]() 3:28
3:28
![Команда Дино. Исследователи Сезон 1]() 13:10
13:10

 3:30
3:30Скачать видео
| 256x144 | ||
| 426x240 | ||
| 640x360 | ||
| 854x480 |
 2:41
2:41
2025-10-22 14:02
 3:40
3:40
2025-10-18 10:34
 4:58
4:58
2025-10-18 10:31
 3:05
3:05
2025-10-17 11:37
 3:20
3:20
2025-10-16 11:19
 2:24
2:24
2025-10-14 12:10
 4:44
4:44
2025-10-19 10:46
 3:36
3:36
2025-10-18 10:07
 5:23
5:23
2025-10-14 11:01
 3:23
3:23
2025-10-16 10:00
 4:00
4:00
2025-10-18 10:19
 2:57
2:57
2025-10-15 10:54
 4:38
4:38
2025-10-23 11:27
 3:13
3:13
2025-10-18 09:47
 2:28
2:28
2025-10-21 09:22
 3:45
3:45
2025-10-15 10:45
 2:26
2:26
2025-10-22 14:10
 3:24
3:24
2025-10-17 11:33
 3:58
3:58
2025-10-17 11:48
 3:08
3:08
2025-10-18 10:28
0/0
 1:53:35
1:53:35
2025-09-11 08:20
 1:26:24
1:26:24
2025-09-03 13:20
 1:36:20
1:36:20
2025-10-09 20:02
 2:36:13
2:36:13
2025-10-07 09:27
 1:58:51
1:58:51
2025-08-27 17:17
 1:35:11
1:35:11
2025-10-13 12:06
 1:31:20
1:31:20
2025-08-27 17:17
 2:09:55
2:09:55
2025-10-05 00:32
 2:05:43
2:05:43
2025-08-27 18:01
 1:54:19
1:54:19
2025-08-27 18:01
 2:02:20
2:02:20
2025-10-01 12:06
 1:34:43
1:34:43
2025-09-09 12:49
 1:33:24
1:33:24
2025-09-19 15:12
 1:49:20
1:49:20
2025-10-21 22:50
 2:01:55
2:01:55
2025-08-28 15:32
 1:34:38
1:34:38
2025-08-28 15:32
 1:33:34
1:33:34
2025-10-08 12:27
 1:50:15
1:50:15
2025-08-27 18:32
 1:48:08
1:48:08
2025-10-24 17:32
 1:41:29
1:41:29
2025-08-15 19:31
0/0
 21:08
21:08
2025-01-09 16:39
 1:04:60
1:04:60
2025-09-02 13:47
 13:00
13:00
2024-11-29 13:39
 3:27
3:27
2024-12-07 11:00
 7:42
7:42
2024-12-17 12:21
2021-09-24 16:00
 12:41
12:41
2024-11-28 12:54
 12:12
12:12
2024-11-29 14:21
2021-09-22 22:40
2021-09-22 22:54
 5:14
5:14
2024-11-28 13:12
 11:22
11:22
2023-05-11 14:51
 7:09
7:09
2023-07-06 19:20
 12:34
12:34
2024-12-02 14:42
 13:42
13:42
2024-11-28 14:12
 7:00
7:00
2025-06-01 11:15
2021-09-22 22:07
2021-09-22 23:09
 3:28
3:28
2025-01-09 17:01
2021-09-22 22:45
0/0

